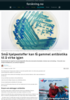

På egen hånd er disse stoffene helt ubrukelige i møte med resistente bakterier. Eller i møte med bakterier i det hele tatt.
De kan altså ikke drepe bakterier slik antibiotika kan.
Likevel kan de bli viktige i kampen mot antibiotikaresistens.
De kan nemlig få gamle antibiotika til å virke igjen.
Men for å forstå hvordan de kan det, må vi inn i bakteriene for å se hva som skjer når de blir resistente.
Enzym som ødelegger antibiotika
Det finnes mange måter en bakterie kan bli resistent mot antibiotika på. Men et fellestrekk er at de kan lage enzymer som stopper medisinen fra å virke.
Bakterier kan enkelt dele disse resistensenzymene mellom seg. Det betyr at bakterier som ikke var resistente, plutselig kan bli det. Og i verden i dag er dette et økende problem.
- Hvis ikke vi klarer å utvikle gode strategier for å behandle resistente infeksjoner kan vi ikke lenger gjennomføre operasjoner, kreftbehandling eller tannlegebesøk, sier Annette Bayer, kjemiker og forsker ved UiT Norges arktiske universitet.
Og det er her hjelpestoffene kommer inn.
Målet er at de skal hindre de resistente bakteriene i å forsvare seg mot en veldig viktig type




































































































